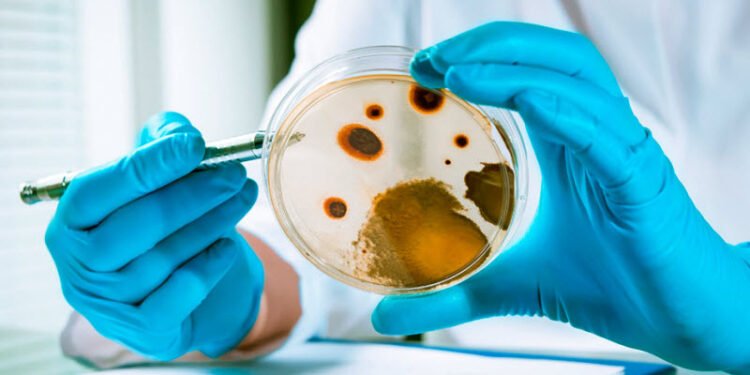
Alertan de contaminación por listeria de leche cruda en el condado de Saratoga

El Comisionado del Departamento de Agricultura y Mercados del Estado de Nueva York, Richard A. Ball, advirtió hoy a los consumidores que no consuman leche cruda no pasteurizada de Charles B. Curtiss dba Willow Marsh Farm debido a una posible contaminación por Listeria monocytogenes. Charles B. Curtiss dba Willow Marsh Farm está ubicada en 343 Hop City Road, Ballston Spa, Nueva York, en el condado de Saratoga. Hasta la fecha, no se han reportado enfermedades al Departamento asociadas con este producto.
Se descubrió que una muestra de la leche recolectada por un inspector del Departamento estaba contaminada con Listeria monocytogenes. El 27 de febrero de 2025, se notificó al productor un resultado positivo preliminar de la prueba. Pruebas de laboratorio adicionales, completadas el 4 de marzo de 2025, confirmaron la presencia de Listeria monocytogenes en la muestra de leche cruda. El productor ahora tiene prohibido vender leche cruda hasta que un muestreo posterior indique que el producto está libre de bacterias dañinas.
El Departamento recomienda que los consumidores que hayan comprado leche cruda de Charles B. Curtiss dba Willow Marsh Farm la desechen inmediatamente y llamen a la granja al (518) 288-3347.
La Listeria monocytogenes causa listeriosis, que puede ser una infección grave y a veces mortal en niños pequeños, pacientes con cáncer, personas mayores y otras personas con sistemas inmunológicos debilitados. La listeriosis puede causar abortos espontáneos y muerte fetal en mujeres embarazadas. También puede causar síntomas similares a los de la gripe a corto plazo, como fiebre alta, fuertes dolores de cabeza, rigidez, náuseas, dolor abdominal y diarrea en personas sanas.
Es importante tener en cuenta que la leche cruda no proporciona la protección de la pasteurización. La pasteurización es un proceso que calienta la leche a una temperatura específica durante un período de tiempo específico. La pasteurización mata las bacterias responsables de numerosas enfermedades, como la listeriosis, la salmonelosis, la campilobacteriosis, la fiebre tifoidea, la tuberculosis, la difteria y la brucelosis. La pasteurización de la leche está reconocida internacionalmente como un medio eficaz para prevenir brotes de enfermedades transmitidas por los alimentos, incluida la listeriosis.